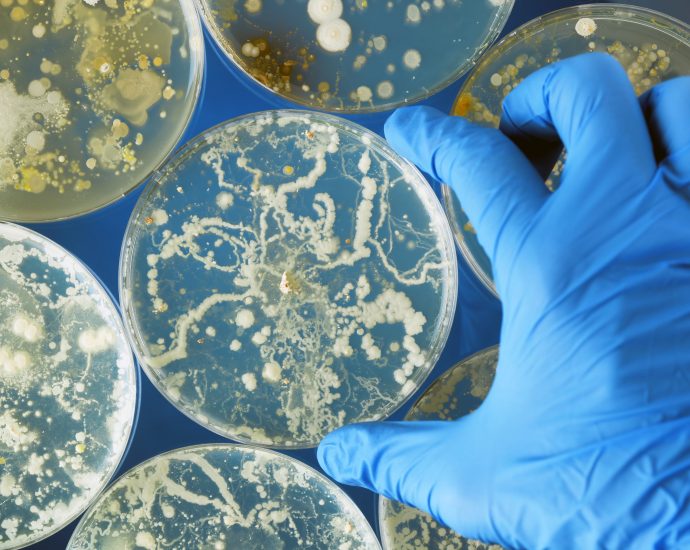

FDA Panel Backs Second RSV Vaccine for Older Americans
THURSDAY, March 2, 2023 (HealthDay News) — Following hours of discussion over safety concerns, a U.S. Food and Drug Administration advisory panel on Wednesday recommended approval of a second RSV vaccine, this one made by GlaxoSmithKline, for use in Americans ages 60 and older. The panel’s recommendation was based largelyContinue Reading